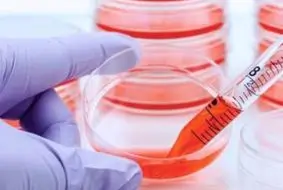

INSERM
INSERM
Custom SignArrays® for cardiovascular research
“The customized SignArrays® developed by AnyGenes® were pivotal in conducting critical analyses published in high-impact journals.”

20+ years of molecular expertise
1,000+ validated pathway panels
Cited in 100+ peer-reviewed publications
Cell signaling research requires precise and reliable tools. AnyGenes® provides over 1,000 experimentally validated qPCR arrays and high-performance reagents, delivering reproducible results even with low-input or challenging samples. Our solutions help researchers uncover molecular pathways, immune response mechanisms, and biomarkers, accelerating breakthroughs in molecular biology.
Trusted partner for over 20 years

Get more than qPCR arrays and gain powerful data analysis software included with every kit. Therefore, you can:
Using AnyGenes® qPCR arrays, researchers uncovered genome-wide transcriptome changes in Cornelia de Lange Syndrome. Moreover, our arrays enabled precise gene expression profiling even with rare or low-input samples.
SignArrays® facilitated detailed analysis of endothelial signaling pathways in pulmonary hypertension studies, providing key insights for translational research and potential therapeutic targets.
Validated lncRNA qPCR assays allowed efficient quantification of lncRNAs in acute myocardial infarction patients, supporting rapid biomarker discovery.

Customize your own signaling pathways (SignArrays®) with the factors of your choice!
Simply download and complete our Personalized SignArrays® information file
and send it at
[email protected]
to initiate your project.
Researchers and clinical teams use AnyGenes® solutions for custom qPCR arrays, signaling pathway analysis, iPSC characterization and mycoplasma detection.
 INSERM
INSERM
“The customized SignArrays® developed by AnyGenes® were pivotal in conducting critical analyses published in high-impact journals.”
 INSERM
INSERM
“The customized SignArrays® developed by AnyGenes® played a crucial role in analyzing 2D and 3D neural cells derived from patients with neurodevelopmental disorders.”
 AP-HP
AP-HP
“We are very satisfied with the quality of the reagent, the delivery times and the response time of the AnyGenes® team.”
1- FORUM LABO PARIS 28-30 MARCH 2023
Please join us at our booth #H105, hall H, to learn more about AnyGenes’s products and molecular services
2- 7th Drug Discovery Summit, 2022-Madrid
AnyGenes will participate to the 7th Drug Discovery Summit, 2022-Madrid. Dr NAIMI, will give a talk on the importance of signaling pathways and biomarkers in the process of drug development, by using AnyGenes molecular platform
3- Importation of biological samples
AnyGenes obtained from The Ministry of Agricultural the authorisation to import biological samples from outside the European Union
4- Distribution agreement with Hölzel Diagnostika
We welcome Hölzel Diagnostika Handels GmbH as new distributor of AnyGenes products and services in Germany, Austria and Switzerland
5- BIO-Europe Spring 2020
AnyGenes will be present at BIO-Europe Spring 2020
6- AnyGenes products and services in JAPAN
We are proud to have signed an agreement with the company Funakoshi, Co, Ltd, for the distribution of AnyGenes products and services in JAPAN
7- BIOFIT 2018, LILLE, 4-5 December
AnyGenes team will be present at BioFIT Event 2018 at Lille, FRANCE
8- Specific Pre-amplification kit
You have small quantity of biological sample but many signaling pathways to explore? AnyGenes® team is proud to help you with our new range of cDNA pre-amplification SpeAmpn system to perform high-throughput analysis with very small amounts of biological material (5 ng RNA) or few cells.
9- MEDICA 2017/ Dûsseldorf, GERMANY, 13-16 NOV
AnyGenes® team was present at MEDICA 2017, the key world forum for medicine. AnyGenes® stays informed of all the news, innovative projects, latest technologies and issues in medical fields in order to offer you innovative products and tools.
10- BioJapan/ Regenerative Medicine Japan 2016
AnyGenes® has been selected by the EU-Japan centre, for BtoB meetings at Osaka from 9-11 October, and to present its products (SignArrays®) and its multi-biomarkers clinical tests at BioJapan 2016, October 12-14, Yokohama, JAPAN.
11- Chinese Medicine Conference 2016
Dr Ju Liya has held a conference at the 2nd World Forum on Astragalus membranaceus, 10 June 2016 at Beijing CHINA. Dr Ju Liya had talked about interesting results from in vitro analysis of compounds from chinese medicine by using AnyGenes® molecular platform.
12- Products
Discover now our various signaling pathways (SignArrays®) and Highly sensitive and specific assay kits for specific gene quantification by real time qPCR array.
